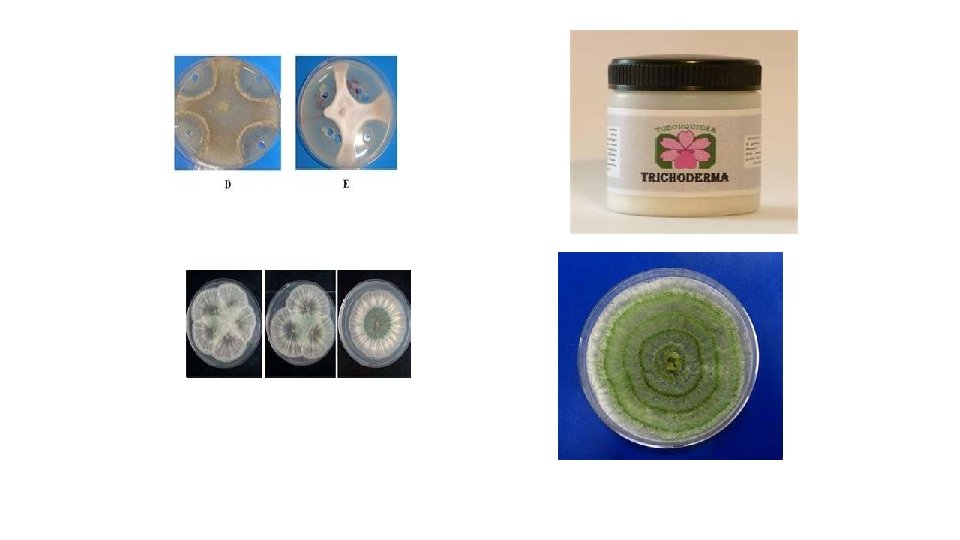

Alterations in Rhizosphere Microflora Foliar application of various

- Slides: 24
Alterations in Rhizosphere Microflora Foliar application of various chemicals leads to alterations in the rhizosphere micro flora by changing the pattern of root exudates. The pattern of the rhizosphere microflora i. e. numbers and species composition can be changed by various factors, such as: (!)Soil amendments, (ii) Foliar application of fertilizers / nutrients, fungicides, insecticides and hormones and (iii) Bacterization / microbial seed inoculants.
A. Soil amendments: Soil amendments with inorganic and organic fertilizers can alter the rhizosphere microflora and an understanding of the type of changes in the micro flora can be useful in the indirect control of pathogens. Amendment of soil with castor and bean leaves stimulate the activity of Trichoderma viride and Penicillium in the rhizosphere leading to the control of Sclerotium rolfsii.
Trichoderma viride Penicillium Sclerotium rolfsii
B. Foliar application of fertilizers and agrochemicals: Translocation of photosynthetic from leaves to roots takes place as a part of the normal metabolic activity in plants. Therefore, organic substances, including plant protection chemicals (fungicides, insecticides), growth regulators and plant nutrients applied to leaves get absorbed into the leaf tissue and further get translocated to roots along with photosynthesis. Foliar application with various chemicals cause marked alterations in the number and kind of microorganisms in the rhizosphere of several cereals and leguminous crop plants.
Thus, such an approach can be used as a new tool in the biological control of root diseases, stimulation of activity of nitrogen-fixing bacteria. C. Seed treatment with bio inoculants: Bio inoculants such as Azotobacter , Azospirillum, Rhizobium or P -solubilizing microorganisms (e. g. Bacillus polymyxa, Azotobacter, Aspergillus niger, Penicillium digitatum. ) When applied to the seed / soil helps in the establishment of beneficial microorganisms in the rhizosphere region which will further benefit in plant growth, encourage inhibition of plant pathogenic organisms in the root vicinity and enrich the soil with added microbial bio-mass.
Associative and Antagonistic activities in the Rhizosphere The composition of microflora of any habitat (soil / rhizosphere) is governed by the biological equilibrium created by the associations and interactions of all individuals found in the community. In soil and rhizosphere region, many microorganisms live in close proximity and their interactions with each other may be associative or antagonistic.
A. Associative interactions / activities in rhizosphere: The dependence of one microorganism upon another for extra-cellular products (e. g. amino acids & growth promoting substances) can be regarded as an associative activity in rhizosphere. There is an increase in the exudation of amino acids, organic acids and monosaccharide by plant roots in the presence of microorganisms. Gibberellins and gibberellins- like substances are known to be produced by bacterial genera viz Azotobacter, Arthrobacter, Pseudomonas, and Agrobacterium which are commonly found in the rhizosphere.
Microorganisms also influence root hair development, mucilage secretion and lateral root development. Fungi inhabiting the root surface facilitate the absorption of nutrient by the roots. Mycorrhiza is one of the best known symbiotic interactions which exist between the roots of higher plants and fungi. This mycorrhizal association has been found to improve plant growth through better uptake of phosphorus and zinc from soil, suppression of root pathogenic fungi and nematodes.
B. Antagonistic interactions in rhizosphere: The biochemical qualities of root exudates and the presence of antagonistic microorganisms, plays important role in encouraging or inhibiting the soil borne plant pathogens in the rhizosphere region. Several mutualistic, communalistic, competitive and antagonistic interactions exist in the rhizosphere. The number and qualities of antagonistic microorganisms in the rhizosphere could be increased through artificial means such as fertilizer application, organic amendments, foliar spraying of chemicals.
Antagonistic microorganisms in the rhizosphere play an important role in controlling some of the soil borne plant pathogens. Stanier et al (1966) discovered the bacterial strain Pseudomonas fluorescens and the fluorescent pigments of this species in biological control of root pathogens. Strains of P. fluorescence are collectively called as "Fluorescent Pseudomonads".
They produce variety of biologically active compounds such as plant growth substances, cyanides, antibiotics and iron chelating substances called "Siderophores" Rovira and Campbell (1975), showed that bacterial strains of P fluorescens could lyse the hyphae of Gaumannomyces graminis var. Tritici, the causative agent of take-all disease of wheat.
Fluorescent pseudomonads (P. fluorescens, P. putida) are known to produce iron chelating substances called Siderophores. These are low molecular weight, extra cellular, iron-binding agents produced by pseudomonads in response to low iron stress or when Fe 3 is in short supply. Thus, iron stress triggers the formation of iron-binding ligands called siderophores. Siderophores contains the pigments Pyoverdine (Fluorescent) and Pyocyanin (non-Fluorescent) having iron chelating properties.
Another pigment "Pseudobactin" is a fluorescent chelator of iron which is known to promote plant growth and inhibition of pathogenic bacteria in the rhizosphere. An antibiotic called "Pyrrolnitrin" reduces damping-off disease in cotton caused by Rhizoctonia solani. Several species of Bacillus are known to cause mycolysis in the rhizosphere. e. g. Fusarium oxysporum hyphae are known to undergo lyses in soil due to these bacterial metabolites.
The successful antagonists among fungi are Trichoderma sp (T. viride and T. harzianum, T. hamatum) and Gliocladium virens which parasitize, lyse or kill the phytopathogenic fungi in the soil. Antifungal and antibacterial actinomycetes in the rhizosphere play an important role in controlling pathogenic fungi and bacteria, for example Micromonospora globosa is a potent antagonist of Fusarium udum causing wilt of pigeon pea. Amoebae are also known to play an antagonistic role in controlling soil fungi, e. g. control of take-all disease of wheat caused by Gaumannomyces graminis through the use of Myxamoebae
Rhizosphere in relation to Plant Pathogens Plant root exudates influence pathogenic fungi, bacteria and nematodes in various ways. The effect may be in the form of attraction of fungal zoospores, or bacterial cells towards the roots; stimulation of germination of dormant spores and hatching of cysts of nematodes. Root exudates may contain inhibitory substances preventing the establishment of pathogens. The balance between the rhizosphere micro flora and plant pathogens and soil micro flora and plant pathogens is important in host-pathogenic relationship.
In this context, the biochemical qualities of root exudates and the presence of antagonistic micro -organisms plays an important role in the proliferation and survival of root infecting pathogens in soil either through soil fungi stasis, inhibition or antibiosis of pathogens in the rhizosphere. Some of the most common interactions between plant roots and plant pathogenic microorganisms in the rhizosphere are discussed herewith.
A. Zoospore attraction: Amino acids, organic acids and sugars in the root exudates stimulate the movement and attraction of zoospores towards root of the plants. For example attraction of zoospores has been reported in Phytophthora citrophthora (Citrus roots), B. Spore germination: The spores or conidia of many pathogenic fungi such as Rhizoctonia, Fusarium, Sclerotium, Pythium, Phytophthora have been stimulated to germinate by the root exudates of susceptible cultivars of the host plants.
This stimulus to germination is especially important to those plant pathogens which are not vigorous competitors and remain in resting stage due to shortage of nutrients or fungi stasis. The quantity and quality of microorganisms present in the rhizosphere of disease resistant crop varieties are significantly different from those of susceptible varieties.
C. Changes in morphology and physiology of host plant: Changes in the physiology and morphology of host plant influence the rhizosphere microflora through root exudations. Systemic virus diseases cause marked changes in the plant morphology and physiology to drastically alter the rhizosphere microflora.
D. Increase in antagonists activity: Root exudates provide a food base for the growth of antagonistic organisms which plays an important role in controlling some of the soil borne plant pathogens. Generally, rhizosphere of the resistant plant varieties harbored more number of Streptomyces and Trichoderma than that of susceptible varieties. High density of Trichoderma viride in the rhizosphere of Tomato varieties resistant to Verticillium wilt has been reported with its ability to reduce the severity of wilt in susceptible plants.
E. Inhibition of pathogen: Root exudates containing toxic substances such as glycosides and hydrocyanic acid may inhibit the growth of pathogens in the rhizosphere. It has been reported that root exudates from resistant varieties of Flax excrete a glucoside which on hydrolysis produces hydrocyanic acid that inhibits Fusarium oxysporum, the flax root pathogen. Exudates of resistant pea reduce the germination of spores of Fusarium oxysporum. In this light, the rhizosphere may be considered as a microbiological buffer zone in which the micro flora serves to protect the plants against the attack of the pathogens.
F. Attraction of bacteria and nematodes: Root exudates attracts phytopathogenic bacteria and fungi in the rhizosphere for example Agrobacterium tumefaciens have been reported to be attracted to the roots of the host plants like peas, maize, onion, tobacco, tomato and cucumber. Host root exudates also influence phytopathogenic nematodes in two ways: (i) though stimulation of egghatching process and (ii) attraction of larvae towards plant roots.